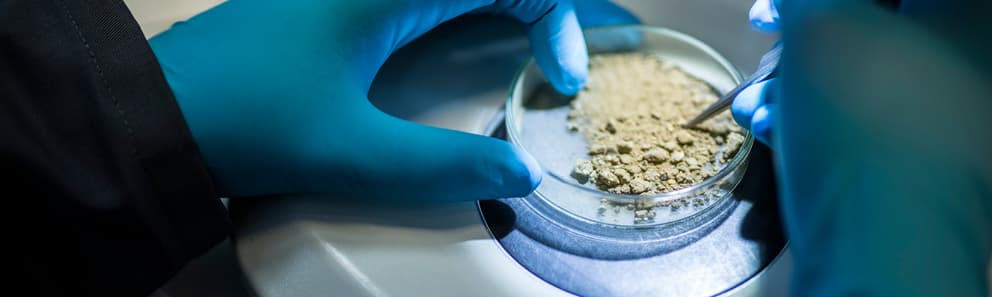

PFAS Testing Services
Element's ISO17025-accredited PFAS Testing Services deliver industry-leading detection capabilities down to parts per trillion, helping you meet increasingly strict regulatory requirements while protecting human health and the environment. Our comprehensive PFAS analysis spans multiple matrices, ensuring you get accurate, reliable results that maintain compliance and safeguard your stakeholders. With dedicated PFAS laboratories and advanced instrumentation, we provide fast-turnaround testing solutions backed by extensive environmental testing expertise.

What is PFAS testing at Element?
Poly- and perfluoroalkyl substances (PFAS) are a large group of synthetic organofluorine chemicals that have been widely used in industry and manufacturing since the 1940s. PFAS compounds are often known as 'forever chemicals' as they do not break down in the environment, and can readily migrate to the air, water, soil, and the food chain.
Element's ISO17025-accredited PFAS Testing Services deliver industry-leading detection capabilities down to parts per trillion, helping you meet increasingly strict regulatory requirements while protecting human health and the environment.

What can Element offer you for PFAS Testing Services?
Key services offered
Key services offered
For laboratory analysis, Element offers USEPA methodology-based testing, Total Oxidisable Precursor (TOP) assay, and custom method development for non-standard PFAS compounds. For our onsite analysis of gaseous PFAS compounds (UK only) we sample to US EPA OTM-45 procedures. Our services include comprehensive field sampling support, appropriate container provision, and fast-turnaround options to meet your urgent testing needs. Additionally, we provide expert consultation on sampling methodologies and contamination prevention strategies to ensure sample integrity from collection through analysis.
Components and Materials We Test
Components and Materials We Test
Our comprehensive testing capabilities cover an extensive range of matrices including drinking water, surface water, groundwater, soil, waste products, emission gases, firefighting foams, and concrete. We specialize in detecting PFAS compounds at the parts per trillion level, ensuring you meet regulatory requirements across all sample types. Our expertise extends to complex matrices and challenging sample types, with customized preparation methods to ensure accurate results regardless of matrix interference.
Cutting-Edge Equipment We Use
Cutting-Edge Equipment We Use
Our state-of-the-art equipment includes multiple Agilent 1290 HPLC 6495 Triple Quadrupole MS systems for superior detection capabilities, plus Biotage automated extraction equipment. This advanced technology ensures precise identification of PFAS compounds at regulatory-required levels without additional sample preparation. For our onsite analysis of gaseous PFAS compounds (UK only) we use selected-ion flow-tube mass spectrometry (SIFT MS). Our investment in the latest analytical technology ensures you receive consistently accurate results that meet or exceed regulatory requirements.
Which Labs Offer This Service
Which Labs Offer This Service
Element's dedicated PFAS testing facilities in Deeside (UK) and Fort Wayne (US) feature specially-designed isolated PFAS laboratories and multiple state-of-the-art instruments. Both facilities maintain ISO17025 accreditation, with Fort Wayne also holding NELAP accreditation for multiple environmental matrices. Our global network ensures convenient access to expert testing services wherever you operate.
End-to-End Sample Support
End-to-End Sample Support
We provide comprehensive sampling guidance and support, including field blanks and deionized water provision, to minimize cross-contamination risks. Our global sample collection services ensure convenience and reliability for international testing needs. Expert consultation is available throughout your testing program to ensure optimal results.
Standards we test to and materials we test
- USEPA methodologies
- EU Drinking Water Directive 2020/2184
- England & Wales Drinking Water Inspectorate (DWI) requirements
- Health Canada directives
- CFIA/FDA directives
- Drinking water
- Surface water
- Groundwater
- Soil
- Waste products
- Firefighting foams
- Concrete
- Ash
- Air emissions
- Consumer products
Your Challenges, Our Solutions
Ultra-Low Detection Requirements
Complex Regulatory Compliance
Multiple Sample Matrix Challenges
Rapid Results Needed
Why Choose Element

Global Recognition & Accreditation
Advanced Technical Capabilities
Comprehensive Testing Solutions
Expert Sample Management
Proof points
50+PFAS compounds tested
2015launch
2dedicated PFAS laboratories

Frequently asked questions
What detection levels can you achieve for PFAS testing?
Our advanced instrumentation achieves detection levels in the parts per trillion range, meeting regulatory requirements without additional sample preparation.
How do you prevent sample contamination?
We provide comprehensive field sampling guidance, appropriate containers, field blanks, and deionized water to minimize contamination risks. We also provide on-site monitoring of specific PFAS compounds in emission in real-time.
What substances do you test?
With more than 5,000 known PFAS compounds, the regulatory landscape is complex and rapidly expanding. Our experienced team support clients by conducting comprehensive testing across an expanding range of matrices, keeping pace with evolving regulations.
We currently offer a target list of up to 50 substances which has been developed to include those 20 PFAS detailed within Annex III of EU Drinking Water Directive 2020/2184, the England & Wales Drinking Water Inspectorate (DWI) Annex A – List of 53 PFAS substances required for monitoring and others routinely requested by our clients. We also offer the specific compounds and methods listed in US EPA, Health Canada and CFIA/FDA directives.

Explore our global network of labs and find your nearest location
VIEW ALL LOCATIONSRelated services

Soil Testing And Analysis Laboratory Services
Element’s soil testing and analysis services include the laboratory analysis of soils, sediments, wastes and leachates to determine the level of nutrients and identify any contamination. Learn More.

Hazardous Materials Testing and Inspection
Element helps you to protect your employees by conducting hazardous materials testing & inspection to manage and safely dispose of any hazardous waste.

Wastewater Testing Services
Element's state-of-the-art wastewater testing laboratories analyze your wastewater samples, deliver accurate results and provide the guidance you need to take the next steps.